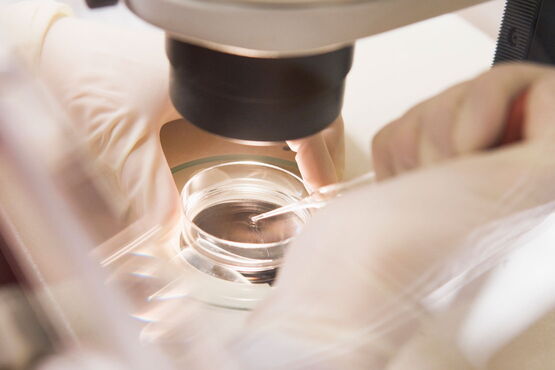
IVF – Befruchtung in der Petrischale IVF – Befruchtung in der Petrischale

Spermienauswahl mit Fertile®Chip
Die Funktionsanalyse der Spermien ist eine relativ neue Therapiemöglichkeit zur Auswahl der besten Spermien und kann die Chance auf eine Befruchtung verbessern.
Der Fertile®Chip ersetzt und erweitert die frühere PICSI®. Dieses Gerät – welches von der Harvard University Medical School und dem Massachusetts Institute of Technology (MIT) patentiert worden ist – wurde entworfen, um die Samenzellen mit der besten Morphologie auszuwählen, die DNA-Fragmentierung zu reduzieren und den Anteil der reaktiven Sauerstoffmoleküle zu senken.
Die Spermien müssen hierbei in einem Objektträger (Chip) chemische und physikalische Mikrobarrieren passieren, was uns eine Auswahl der besten Spermien erlaubt. Hierbei macht man sich die natürliche Auslese der Spermien im weiblichen Fortpflanzungstrakt zu eigen. Nachweislich haben die so ausgewählten Spermien eine geringere Rate genetischer Defekte und eine deutlich höhere Befruchtungsfähigkeit als unsortierte Spermien.
Der Fertile®Chip kann grundsätzlich zur Verbesserung der Befruchtungsrate bei allen Techniken der Reproduktionsmedizin (IUI, IVF, ICSI) eingesetzt werden. Die Kosten werden von den Krankenkassen nicht übernommen und betragen 285 €.
FAQ: Fertile®Chip
Was ist der Fertile®Chip und wie hilft er bei der Kinderwunschbehandlung?
Der Fertile®Chip ist eine von der Harvard Medical School und dem MIT entwickelte Technologie zur Auswahl der qualitativ besten Spermien. Er ahmt den natürlichen Selektionsprozess im weiblichen Körper nach und verbessert so die Befruchtungsrate bei Kinderwunschbehandlungen nachweislich.
Wie funktioniert die Spermienauswahl mit dem Fertile®Chip bei Kinderwunsch?
Die Spermien müssen in einem speziellen Objektträger chemische und physikalische Mikrobarrieren passieren – ähnlich dem natürlichen Weg zur Eizelle. Nur Spermien mit optimaler Beweglichkeit, Morphologie und intakter DNA schaffen diese Passage und werden für die Behandlung verwendet.
Welche Vorteile hat der Fertile®Chip gegenüber herkömmlicher Spermienaufbereitung bei Kinderwunsch?
Die mit dem Fertile®Chip selektierten Spermien weisen nachweislich eine geringere Rate an genetischen Defekten und eine deutlich höhere Befruchtungsfähigkeit auf als durch konventionelle Aufbereitung gewonnene Spermien – das verbessert sowohl die Befruchtungsrate als auch die Chancen auf eine gesunde Schwangerschaft.
Bei welchen Kinderwunsch-Behandlungsmethoden kann der Fertile®Chip eingesetzt werden?
Der Fertile®Chip ist universell einsetzbar – bei Insemination (IUI), IVF und ICSI. Er ergänzt das jeweilige Verfahren und kann die Ergebnisse bei allen drei Methoden verbessern.
Für wen ist der Fertile®Chip bei Kinderwunsch besonders empfehlenswert?
Besonders sinnvoll ist der Einsatz bei eingeschränkter Spermienqualität, erhöhter DNA-Fragmentierung, vorangegangenen Befruchtungsversagen oder wiederholten Fehlgeburten. Grundsätzlich kann jedoch jedes Paar von der präziseren Spermienauswahl profitieren.
Übernimmt die Krankenkasse die Kosten des Fertile®Chip bei der Kinderwunschbehandlung?
Nein. Der Fertile®Chip gilt als Zusatzleistung und wird von gesetzlichen Krankenkassen nicht übernommen. In einem persönlichen Gespräch erläutern wir Ihnen gerne, ob und in welchem Umfang der Einsatz für Ihre individuelle Situation sinnvoll ist.